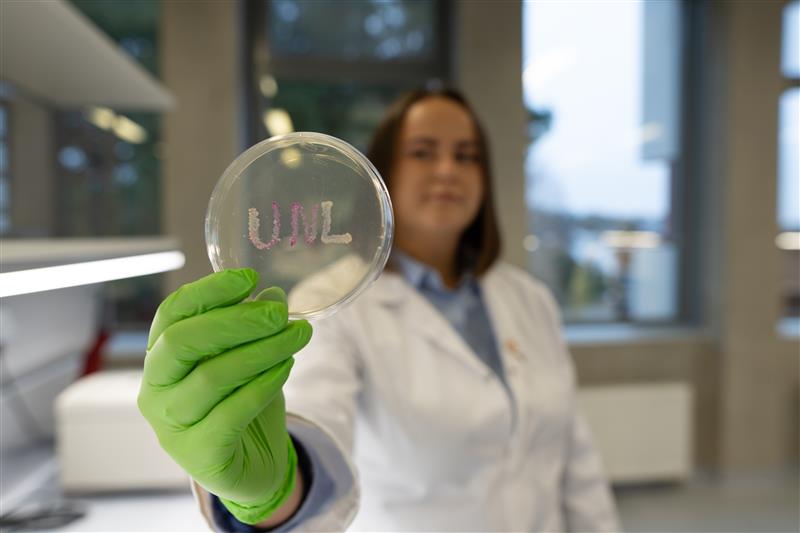

At “Comic Con Baltics” Festival – A Glimpse into the World of Life Sciences
On May 22-23, Rusnė Uzielaitė and other representatives of Vilnius University Life Sciences Center invited “Comic Con Baltics” visitors for a closer look at scientific activities.